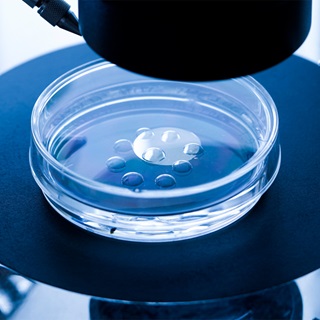
donor-sperm-insemination-1290x1290

Infertility in Women

Overview
Maternal age is the most significant factor related to a woman's ability to conceive. While many women today are waiting to become pregnant, the ovary's ability to produce normal, healthy eggs declines with age, increasing the risk of chromosomal abnormalities and unsuccessful implantation and pregnancy.
The likelihood for successful pregnancy begins to decrease in women in their early 30s. While this decline is initially quite minimal, as the years pass the rate of decline increases and begins to rapidly accelerate around age 37 to 38, with an acute fall beyond 42 years of age.
Other factors, such as endometriosis and uterine fibroids can also play a role in infertility, though many women with these conditions conceive healthy children without trouble.
Many doctors recommend that women past age 35 have a fertility evaluation after attempting pregnancy for six months. Couples under age 35 should consider evaluation if they don't conceive after trying for a year. A woman using donor insemination should ask her doctor about an infertility evaluation after six months.
Our Approach to Infertility in Women
UCSF is a leader in reproductive health, achieving consistently high pregnancy rates, and we offer a comprehensive array of evaluation and treatment options for women with fertility concerns. We recognize that the process of resolving infertility can be difficult, and we are committed to caring for each patient with knowledge, understanding and respect.
Treatment for female infertility depends on the underlying condition. Surgery or medication may effectively address certain disorders. For patients who don't respond to these therapies or who have fertility issues of unclear origin, we offer the latest assisted reproductive technologies. These include the full range of in vitro fertilization (IVF) procedures, along with state-of-the-art techniques developed here at UCSF that can enhance the effectiveness of IVF.
Awards & recognition
-

Among the top hospitals in the nation
Causes
A woman's age is probably the most significant factor related to her ability to conceive. In addition to age, there are a number of conditions that can interfere with a woman's fertility, including endometriosis, polycystic ovarian syndrome, pituitary tumors and pelvic inflammatory disease.
Endometriosis
Endometriosis occurs when tissue from the membrane lining the uterus, called the endometrium, grows outside the uterus. Between 25 and 50 percent of infertile women are estimated to have this condition.
This tissue acts just like the endometrium in accumulating blood in the monthly menses period, but it has no place to shed the blood at the end of the cycle. The accumulation of tissue and blood can lead to inflammation, scarring and other problems. Symptoms include pain and cramping before and during periods, pain during intercourse, fatigue, diarrhea, constipation, nausea and infertility. Keep in mind, however, that all of these symptoms can occur with other conditions.
Endometriosis is diagnosed by looking into the pelvic cavity with a viewing instrument called a laparoscope. It can be treated with drugs or surgery to remove the cysts. Women who are not planning to have children or are nearing menopause may consider hysterectomy, the surgical removal of the uterus.
Pelvic inflammatory disease
Pelvic inflammatory disease (PID) in the female reproductive organs often occurs after a sexually transmitted disease such as gonorrhea or a chlamydia infection, or after miscarriage, abortion or childbirth. Symptoms include abdominal pain and tenderness, fever and an unpleasant-smelling vaginal discharge. Repeated attacks may occur with or without reinfection. About 20 percent of infertility is attributed to scarring from PID.
PID usually is diagnosed during a pelvic examination, although samples of discharge may be analyzed. Antibiotics are the usual treatment. Surgery or in vitro fertilization (IVF) is used to treat infertility resulting from PID.
Pituitary tumors
Pituitary tumors, although usually benign, can lead to destruction of some of the hormone-secreting cells in the pituitary gland, causing cessation of menstrual periods in women and reduced sperm production in men. Because of their location, these tumors also can cause visual field defects.
Pituitary tumors are diagnosed by measuring hormone levels in the blood and urine, from MRI or CT scans of the brain and by visual field tests. Treatments include surgical removal of the tumor, radiation therapy, hormone replacement therapy or a combination.
Polycystic ovarian syndrome
In polycystic ovarian syndrome (PCOS), there is a long-term inability to release eggs to the uterus, where they can be fertilized — a process called ovulation. Elevated insulin levels stimulate excess production of the hormone androgen, which cause some of the unfertilized eggs to disintegrate, leading to inconsistent or no ovulation. Most women with PCOS have multiple benign cysts in their ovaries.
Symptoms include irregular ovulation and menstrual periods, obesity, insulin resistance, acne and excessive hair growth. PCOS, the number one cause of infertility, occurs in about 10 percent of all women, with about 30 percent of all women having some characteristics of PCOS.
PCOS is diagnosed by blood tests and ultrasound. Treatments include weight loss, medications including hormones, medications to treat the insulin resistance associated with PCOS, or surgery to remove a portion of the ovary or to drill holes in the ovary with a laser to reduce androgen production.
Evaluation
The basic infertility evaluation for women includes a medical history and a physical examination. Additional testing to further refine the diagnosis is often completed as well.
Medical history
The evaluation typically starts with a careful history of each woman's symptoms and previous experiences. This can include:
- A review of the pattern of menstrual cycle bleeding to help determine if ovulation is occurring and if other problems — such as aging of the ovary, or uterine defects like fibroids or polyps — are present.
- Collecting information that might suggest an anatomic problem with the tubes, such as questions about past history of sexually transmitted infections, painful periods or intercourse, and/or a previous abdominal surgery.
- Questions about previous surgery to the cervix or freezing for abnormal cervical cancer screening test results.
- A general review of systems to determine if other endocrine abnormalities might be contributing to infertility.
- A careful social history to evaluate for any environmental exposures or social habits such as smoking, drinking alcohol, drug use or extreme exercise, which could contribute to infertility.
Physical exam
Next, a physical examination is performed to evaluate the pelvic organs and assess potential hormonal problems.
Laboratory testing
Finally, additional hormonal testing or ultrasounds may be required to evaluate ovulation and ovarian age. An X-ray of the uterus and tubes, called a hysterosalpingogram or HSG test, may be completed to assess uterine or tubal status.
Surgical procedures — such as a laparoscopy, which uses tiny incisions and a scope to view the interior organs, or hysteroscopy, an endoscopic inspection of the uterus — may be indicated to evaluate the structure of the uterus or fallopian tubes in more detail.
Treatment
Treating specific illnesses such as endometriosis may or may not treat the fertility problem. At least 10 percent of infertility problems are due to unknown causes and another 30 percent are due to problems in both the male and female partners.
In addition to medication and surgical infertility treatments to treat specific health conditions in men and women, a new class of treatments — called assisted reproductive technologies, or ART — has been developed. The most common ART is in vitro fertilization, or IVF, but new procedures can enhance the IVF process or address other infertility conditions. These procedures include:
- In Vitro Fertilization
- Intra-Uterine Insemination
- Ovulation Induction
- Male Treatments
In vitro fertilization (IVF)
In vitro fertilization, or IVF, involves fertilization in a laboratory and then the transfer of embryos into the uterus. This procedure was first used for humans in 1977 at Bourne Hall in Cambridge, England, and tens of thousands of babies have been delivered worldwide as a result of IVF treatment.
Over the years, IVF procedures have become increasingly simple, safe and more successful.
To accomplish pregnancy as a result of IVF, several steps are involved:
- Step 1 Stimulation of the ovary to produce several fertilizable oocytes (eggs)
- Step 2 Retrieval of the oocytes from the ovary
- Step 3 Fertilization of the oocytes and culture of the embryos in the IVF laboratory
- Step 4 Placement of the embryos into the uterus for implantation, called embryo transfer (ET)
Some types of infertility that may be helped with IVF include:
- Absent fallopian tubes or tubal disease that can't be treated by surgery
- Endometriosis that doesn't respond to treatment
- Genetic diseases that result in miscarriage or abnormal births
- Infertility secondary to sperm antibodies
- Male infertility caused by a low sperm count, but with enough active sperm to fertilize in the laboratory
- Male infertility in which sperm must be obtained surgically
- Unexplained infertility that doesn't respond to other treatments
UCSF offers the following procedures in conjunction with IVF:
- Egg (ovum) donor program
- Embryo and semen freezing (cryopreservation)
- Pre-implantation genetic diagnosis
Assisted hatching
Assisted hatching involves mechanical or chemical thinning of the outer shell, called the zona pellucida, of the fertilized egg prior to transfer into the uterus. The technique is used to enhance the embryo's ability to hatch or break out of its protective shell and implant in the uterus.
The procedure involves measuring the thickness of the outer shell of embryos. If an embryo has not initiated the thinning process naturally, a small "window" or hole is created chemically using a dilute acidic solution on the embryo surface. The embryos are then implanted normally into the uterus.
The most extensive experience with assisted hatching has been reported from Cornell University where implantation rates are 25 percent per embryo, as compared to 18 percent per embryo with regular IVF in non-assisted cycles.
You may be a candidate for assisted hatching if you are 38 years of age or older, or if you have previously had one or more IVF cycles with failure of your embryos to implant despite otherwise good results.
Blastocyst (embryo) culturing
Blastocyst culturing is a technique to grow embryos beyond the third day of culture. Typically, we transfer embryos into the uterus about three days after the egg retrieval, which is several days earlier than would occur in nature. On the third day, embryos generally are between six to eight cells. We now have the ability to keep the embryos two additional days in a culturing material before implanting in the uterus. During this additional culture period, the embryos continue to grow to become "blastocysts."
The natural process of embryo development begins with fertilization of the egg in the outer part of the fallopian tube. As the newly formed embryo develops, it moves slowly toward the uterine cavity where it will ultimately implant. This process takes about six to seven days. When the embryo reaches the "blastocyst" stage, it is ready to implant.
In certain patients, blastocyst culturing allows optimal selection of embryos for transfer and an increased implant rate. However, this technology may not necessarily increase your chance for pregnancy. The main advantage is that fewer embryos may be transferred to eliminate the possibility of triplet and quadruplet pregnancies, while maintaining a high pregnancy rate.
Embryo co-culturing
Embryo co-culturing was initiated in the IVF lab at UCSF Medical Center in 1999 to improve the quality of embryos prior to transfer into the womb. This technique has been used since 1996 in other centers. It involves using a buffalo rat liver cell line to secrete nutritional products that help growing embryos improve their chances for survival. This technique is only recommended to patients who have had unsuccessful IVF cycles with poor embryo quality.
Intracytoplasmic sperm injection (ICSI)
Intracytoplasmic sperm injection, or ICSI, is the direct microinjection of a single sperm into a single egg to achieve fertilization. It was originally developed in 1992 to assist fertilization in couples with severe male factor infertility or couples who failed to fertilize in a previous IVF attempt.
The procedure overcomes many barriers to fertilization and allows couples with little hope of pregnancy to obtain fertilized embryos. The procedure was first used at UCSF Medical Center in 1994 and the first successful birth with ICSI assistance was in February 1995. UCSF Medical Center was the first San Francisco Bay Area program to achieve a pregnancy and birth with this procedure.
The technique involves very precise maneuvers to pick a single live sperm and inject it directly into the center of a human egg. The procedure requires that the female partner undergo ovarian stimulation with fertility medications so several mature eggs develop. These eggs are suctioned through the vagina, using vaginal ultrasound, and incubated under precise conditions in the embryology lab.
The semen sample is prepared by spinning the sperm cells through a special medium. This solution separates live sperm from debris and most of the dead sperm. The specialist picks up the single live sperm in a glass needle and injects it directly into the egg.
The current fertilization rate of eggs injected is 70 to 80 percent, and pregnancy rates are comparable to those seen with IVF in couples with no male factor infertility.
Please read FAQ: Intracytoplasmic Sperm Injection (ICSI) for more information about this procedure.
Intra-uterine insemination (IUI)
Intra-uterine insemination (IUI), also known as artificial insemination, is the process of preparing and delivering sperm so that a highly concentrated amount of active motile sperm is placed directly through the cervix into the uterus. The current IUI pregnancy rate per treatment at UCSF Medical Center is 14 to 15 percent. It can be performed with or without fertility drugs for the female patient.
The pregnancy rate is double that from using timed intercourse. IUI is commonly performed as a low-tech, cost-effective approach to enhancing fertility.
Please read Intra-Uterine Insemination for more information about this procedure.
Ovulation induction
Historically, oral drugs containing hormones were designed to induce ovulation in women with irregular menstrual cycles who didn't ovulate. The goal was to stimulate the body to produce and release an egg ready to be fertilized.
Later, injected hormones were developed to increase the number of eggs reaching maturity in a single cycle, increasing chances for conception. These drugs increase the risk of multiple conceptions, are more expensive, require more time and may cause ovarian over stimulation.
In the mid-90s, oral drugs were used in women with regular menstrual cycles who ovulate but who have "unexplained infertility." The drugs may treat subtle unidentified defects in ovulation and induce the maturity of two to three eggs, instead of just one, to improve both the quality and quantity of ovulation and enhance pregnancy rates.
Ovulation induction is always combined with intrauterine insemination, and it should only be considered after a complete and thorough evaluation. All underlying hormonal disorders such as thyroid dysfunction should be treated prior to resorting to using fertility drugs.
The following common fertility drugs are used for ovulation induction:
- Clomiphene Citrate — Seraphene and Clomid
- Human Menopausal Gonadotropin (hMG) — LH/FSH (Pergonal, Humegon, Repronex)
- Follicle Stimulating Hormone (FSH)
- Human Chorionic Gonadotropin (hCG) — Profasi or Pregnyl
- Leuprolide (Lupron) and Synthetic Gonadotropin (FSH/LH) Inhibitor
Please read Ovulation Induction to learn more about these drugs.
UCSF Health medical specialists have reviewed this information. It is for educational purposes only and is not intended to replace the advice of your doctor or other health care provider. We encourage you to discuss any questions or concerns you may have with your provider.
More treatment info
-

Cryopreservation
Embryos are stored at low temperatures and can be thawed later for more opportunities for conception.
Learn more -
Donor Sperm Insemination
Donor sperm can be used with in vitro fertilization (IVF) or intrauterine insemination (IUI).
Learn more -

Intrauterine Insemination (IUI)
The procedure delivers a highly concentrated amount of sperm directly into the uterus to enhance fertility.
Learn more -

In Vitro Fertilization (IVF)
Procedures to achieve IVF pregnancy have become increasingly simpler, safer and more successful than in the past.
Learn more























